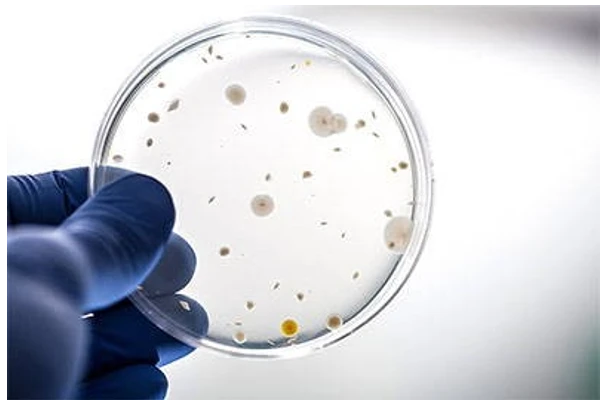
CFU: What it is and How Much Do You Need

CFU stands for colony-forming unit — the number of live, viable microorganisms in a probiotic that are able to divide and grow into a visible colony. It counts only living cells capable of reproducing, not dead ones, which is why CFU, measured in each capsule or powder serving, reflects the active dose you actually receive.
If you've ever shopped for a probiotic supplement, you've probably come across the term “CFU” on a label. But what does CFU stand for? Does a higher CFU probiotic mean a better one? And how can you find out if you're taking too high a CFU for your age and needs? We'll tackle these questions and work to dispel some of the myths surrounding probiotics so that you can make the best decision for your health needs.
What is CFU? What does CFU stand for?
Simply speaking, CFU stands for “colony forming unit”, which describes the number of cells that can multiply to form a colony. So why don't we just use the number of cells rather than colony-forming units when we count probiotics? The answer goes back to the historical methods of laboratory research of bacteria.
Microbiology, or the study of microbes like bacteria, algae, archaea, fungi, and viruses, is one of the oldest fields of biology, dating back to the 17th century. Traditionally, microscopes were the only method available to count bacteria, which were typically grown in vials of broth or grown in little plates of solid material called agar.
Each individual bacterial cell that is healthy should be capable of dividing over and over again, forming a colony of bacterial cells. On an agar plate these colonies can be counted individually by the naked eye and total CFU can be estimated from that count. And on a probiotic label, CFU represents the number of live cells contained in each serving. They're usually counted in the billion and can range from 2 billion to 75 billion.
When To Choose Lower CFU
There are generally 2 situations in which a lower CFU is preferable to a higher CFU. One is related to age. A young infant under the age of 6 months should have no more than 1-2 billion CFU simply due to their size as well as the natural lack of diversity in their gut. Toddlers aged 6 months to 3 years also need a low CFU, within the ballpark of 2-6 billion. Children 3 years old and up need a lower CFU than adults, between 4-25 billion.
Outside of those ages, some adults do need lower probiotic concentrations. This is especially important for those who are already very sensitive to supplements, already have very inflamed gastrointestinal tracts, and those who have autoimmune conditions like MCAS. Of course, there are many other possible health conditions that may make an individual more sensitive to probiotics. The way to find out if you're sensitive is to start with a lower concentration, or CFU, and increase the dose until you notice some changes in your digestion or overall health.
What Is CFU in Probiotics? When to Go for a Higher CFU Probiotics?
So you're a full grown adult without severe leaky gut, severe health conditions, or sensitivity to supplements but you're wanting to improve your overall health or quickly deal with that annoying chronic constipation. You're probably ready for some strong probiotics, maybe even with some prebiotic supplements to give them some fuel to help them hit the ground running. In that case, feel free to indulge in a whopping 25-70 billion CFU.
Of course, you may feel the need to back off on the dosage for a beat if any temporary die off symptoms like gas, bloating, loose stool or headaches get in the way of your daily life. On the other hand, if you start with a lower CFU like 25 billion and you don't feel any improvements in your digestion or energy level, try doubling up to see if a higher CFU will move the needle.
How To Know if You're Probiotic CFU is Too High
This is very important. It is entirely possible to have too much of a good thing. Some people have reported a sudden onset of chronic diarrhea (lasting longer than 1 week) when taking probiotics with a total CFU per dose of 70 billion or higher. If you're a person who has a severe medical condition, abdominal pain due to gut issues, or severe leaky gut, then too high of a dose of CFU can register as intolerable side effects.
In all of these cases, the best way to see if your symptoms are caused by too high of CFU is to take the probiotics every other day or try to take half the dose and see if that lessens the symptoms. If it does, then you can take the lower dose until you feel ready to scale up.
Don't Forget to Factor in the Power of Prebiotics
Prebiotic powders like inulin, Jerusalem artichoke, triphala powder, FOS and XOS can help boost a probiotic supplement's effectiveness when taken at the same time or even in the same capsule. Since they can be so good at helping probiotics to expand quickly, some people with sensitive digestive tracts or other severe health conditions may want to be very calculated in which prebiotics to take, when to take them, and how much.
If you think of prebiotic supplements as fertilizer for your favorite plants, then it might be easier to take into consideration how important gentle dosing is for the health of the plant. Finding the right amount of prebiotic to take can make the difference between helping a struggling probiotic to grow or giving prebiotics to a probiotic population that you already have enough of.
Finding the CFU That's Right For You
When it comes to the question of finding the best probiotic for you, it isn't always about cranking the CFU up as high as you can possibly tolerate. There are some critical factors to take into consideration when looking around:
- Which prebiotics are included (if any)
- How old you are
- How sensitive you are to supplements
- How robust your digestive system is
- Which probiotic strains are included
- How quickly you're looking for results
This may sound like a lot of factors but they all play a part in helping to make your probiotic supplement uniquely tailored to your needs. And when you know more about what your needs and can tolerate, it makes it that much easier to meet those needs. Knowing how high your probiotic concentration (CFU) should be is a great place to start.
CFU is a guess. Your gut isn't.
See what your gut actually needs →Flore sequences 23,000+ microbes in your gut, then formulates the exact strains and dose for you — no more guessing at the billions on a label.
The units family: CFU is one of three ways precision-microbiome science counts what’s in your gut. See PFU, the plaque-forming unit that counts bacteriophages, and AFU, the flow-cytometry viability count that catches living cells a CFU plate can miss.
Stop guessing at CFU. Test, then match.
A number on a label can't tell you which strains your gut is missing or how much you need. Flore's approach: test your microbiome, get a synbiotic matched to your results at the right dose, then re-test to confirm it's working.
Get your personalized formula →CFU FAQ
Is a higher CFU probiotic better?
Not necessarily. A higher CFU isn't automatically better — the right dose depends on your age, gut sensitivity, the strains included, and your goals. Very high counts (70 billion+) can cause diarrhea, bloating, or headaches in sensitive people, while infants and children need far lower doses. Matching the right strains to your gut matters more than maximizing the number.
How many billion CFU do I actually need?
Most healthy adults do well in the 25–70 billion CFU range, while sensitive individuals, children, and infants need much less (1–25 billion). The most reliable way to find your number is to base it on your actual gut microbiome rather than picking the label with the biggest count.
Can you take too much CFU?
Yes. Some people report chronic diarrhea, gas, or cramping at doses of 70 billion CFU or higher, especially with leaky gut, IBS, or autoimmune conditions. If that happens, cut back to every-other-day or a half-dose, then scale up slowly.